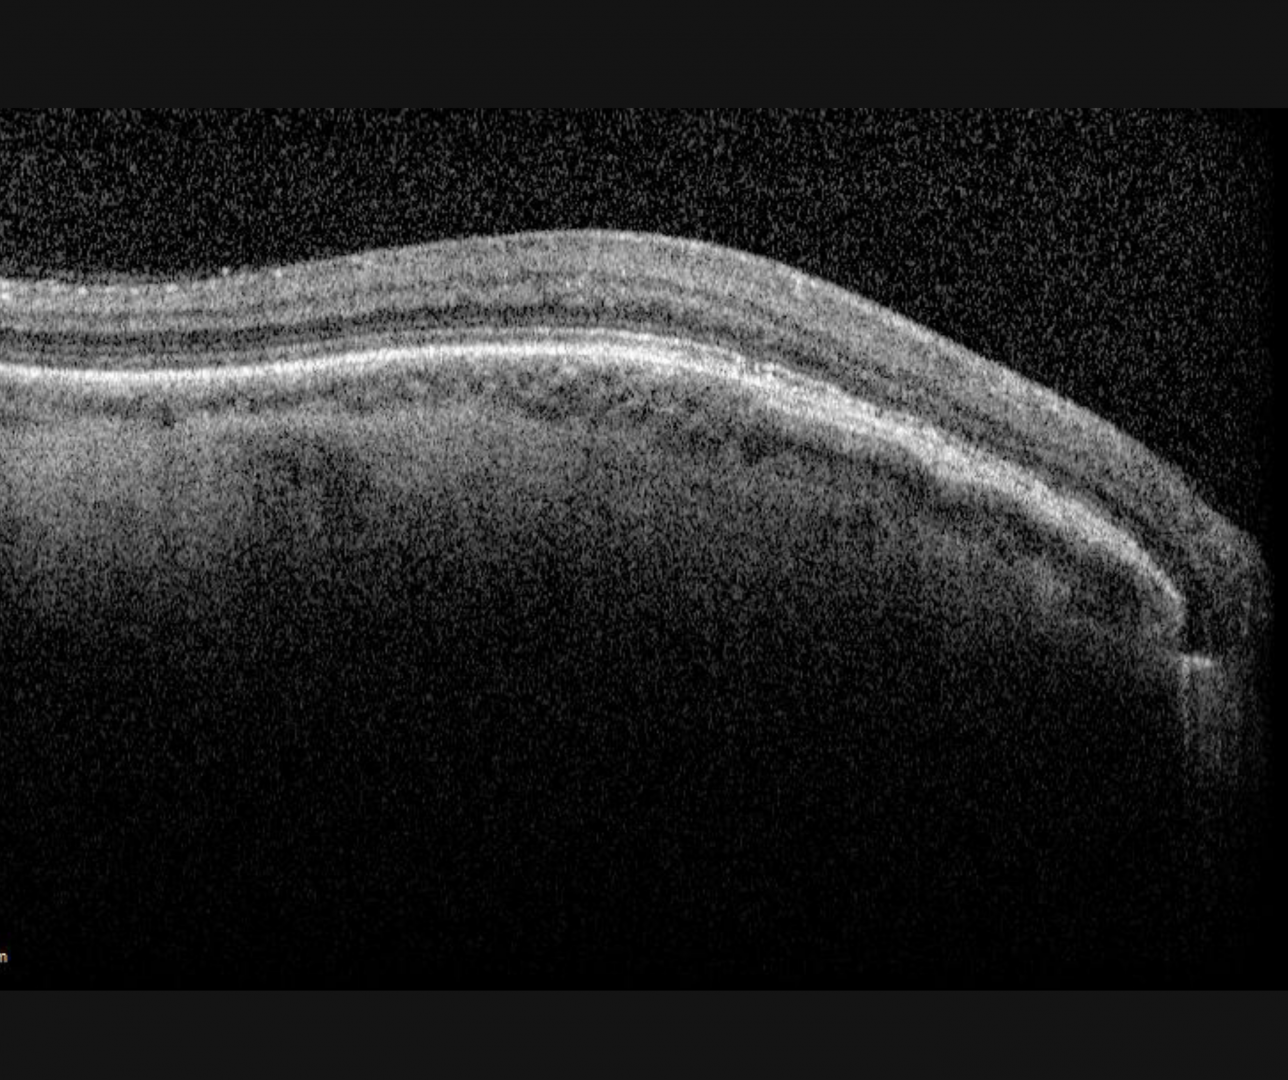

Overview

Albinism is an inherited condition involving an abnormality in melanin pigment production or impairment of the maturation of melanosomes. Oculocutaneous albinism affects the eyes, skin, and hair and is an autosomal recessive disorder. Ocular albinism affects the eyes only and typically shows an X-linked inheritance pattern. It is caused by mutations in GPR143 gene.
Ocular albinism is characterised by reduced visual acuity, nystagmus, various grades of iris translucency, fundus hypopigmentation and foveal hypoplasia. Foveal hypoplasia is caused by the underdevelopment of the foveal pit and has been associated with poor visual acuity. The foveal pit and the foveal avascular zone are either reduced or absent. Another characteristic sign is chiasmal misrouting, which refers to an increased number of retinal ganglion cells from the temporal retina projecting to the contralateral hemisphere and can be detected by visually evoked potential (VEP).
Female carriers of X-linked ocular albinism type can show partial iris translucency and scattered areas of depigmentation but are otherwise asymptomatic.
Case Examples
-
Case 1
A 21-year-old Caucasian female with best-corrected acuities of 6/7.5 (20/25) in each eye.
Fundus photography and red-free image (right eye)
More infoFundus photography and red-free image (left eye)
More infoOptomap images (right and left eye)
More infoAnterior eye photo (right eye)
More infoSpectralis OCT line scan (right macula)
More infoSpectralis OCT line scan (left macula)
More info -
Case 2
A 47-year-old female with nystagmus and best-corrected acuities of 6/75 (20/250) in the right eye and 6/60 (20/200) in the left. Slit-lamp examination revealed marked iris transillumination defects.
-
Case 3
A 26-year-old male with best-corrected visual acuity of 6/7.5 (20/25) in each eye.
Fundus photography (right and left)
More infoOptomap images (superior and inferior retina, right and left eyes)
More infoGreen separation images (superior and inferior retina, right and left eyes)
More infoAnterior eye photo (1) and retroillumination (2)
More infoSpectralis OCT volume and line scans (right macula)
More infoSpectralis OCT volume and line scans (left macula)
More info
Differential Diagnosis
Foveal Hypoplasia
Foveal hypoplasia can also occur in several conditions including achromatopsia, aniridia, microphthalmos, retinopathy of prematurity, Incontinentia pigmenti and Stickler syndrome and can also be an isolated idiopathic condition.
References
Kruijt CC, de Wit GC, Bergen AA et al. The Phenotypic Spectrum of Albinism. Ophthalmology 2018; 125: 1953-1960.
Thomas MG, Kumar A, Mohammad S et al. Structural Grading of Foveal Hypoplasia Using Spectral-Domain Optical Coherence Tomography: A Predictor of Visual Acuity? Ophthalmology 2011; 118: 1653-1660.
Apkarian P, Reits D, Spekreijse H et al. A decisive electrophysiological test for human albinism. Electroencephalography and Clinical Neurophysiology 1983; 55: 513-531.
Kondo H. Foveal hypoplasia and optical coherence tomographic imaging. Taiwan J Ophthalmol 2018; 8: 181-188.